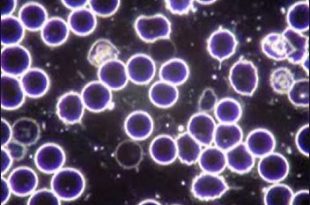

Mihnea Codrescu | Se știe că inversarea valorilor reprezintă esența arsenalului satanist.
Read More »Dacă ești nou pe site
Microzimele – Taina Vieții (I)
Sterie Ciumetti | Descoperitoril microzimelor, Antoine Bechamp, a locuit 12 ani la București.
Read More »Barbarul ritual al tăierii împrejur
Sterie Ciumetti | Un obicei condamnabil despre care se tace la nivel internațional.
Read More »Știrea Săptămânii: Florin Cîțu îl demite, noaptea ca hoții, pe Octav Bjoza, președintele Asociației Foștilor Deținuți Politici, pentru ‘reducerea dimensiunii holocaustului’
Sterie Ciumetti | Tabloul complet al demiterii lui Octav Bjoza de către Florin Cîțu, un reportaj Incorect Politic.
Read More »Nu am tras primul, ci ultimul!
Colonel (rtg.) Vasile I. Zărnescu | Și foarte târziu!
Read More »EXPLOZIV! Ultimul Interviu cu autorul Mihai Șerban
Sterie Ciumetti | Ultimul interviu cu Mihai Șerban.
Read More »Bătrânul colonel Vasile Zărnescu nu a tremurat, a tras primul!
Mihnea Codrescu | Trebuie să lămurim cazul "Vasile Zărnescu", e vital
Read More »Despre naționalismul românesc și A.U.R. – Sterie Ciumetti în dialog cu profesorul Corvin Lupu [II]
Sterie Ciumetti | Răspunsuri la întrebările grele despre naționalismul românesc.
Read More »Ne-au vârât în stalinism: Colonelul (rtg.) Vasile I. Zărnescu a fost condamnat la închisoare pentru că a publicat studii despre holocaust
Sterie Ciumetti | Și noi suntem Vasile Zărnescu.
Read More »INCREDIBIL: autorul naționalist Mihai Șerban și-a organizat evadarea din pușcărie! În exclusivitate pentru Incorect Politic, planul de evadare!
Mihai Șerban | Dincolo de sârma ghimpată.
Read More »Dialog cu profesorul Corvin Lupu. Opinii despre România sub presiunea virușilor și despre noua conducere de la Washington (III)
Sterie Ciumetti | Interviu exclusiv cu Corvin Lupu, singurul român care a câștigat un proces cu jidanii.
Read More »Dialog cu profesorul Corvin Lupu. Opinii despre România sub presiunea virușilor și despre noua conducere de la Washington (II)
Sterie Ciumetti | Partea a doua a dialogului cu prof. univ. Corvin Lupu
Read More »Dialog cu profesorul Corvin Lupu; Opinii despre România sub presiunea virușilor și despre noua conducere de la Washington (I)
Sterie Ciumetti |
Read More »Resetarea Medicinei sau Resetarea Omenirii prin Nanotehnologie
Redacția Internațională | Perspectiva transumanismului.
Read More »Interviu cu descoperitorul virusului HIV, Luc Montagnier, Nobel de Medicină
R.I. | Interviu exclusiv.
Read More »Sociologia Eliberării și Curentele Laterale de Sedimentare Revoluționară
Incorect Politic | Naționalismul revoluționar.
Read More »Vaccinarea înseamnă crimă, un atentat la sănătatea personală, la integritatea corporală și intimitatea oricărui om liber. Medicul ce vaccinează cu forța un om liber merită să fie pedepsit de acesta
Maica Pelaghia | Să ne apărăm cu orice preț, inclusiv cu prețul vieții.
Read More »Profesorul Corvin Lupu: Cititorilor mei, iubitori de adevăr…
Corvin Lupu | Puterea cuvântului adevărat este încă cea a unui sfredel în societatea regimului euro-atlantic...
Read More »Evreul Petre Roman: “Sunt bucureștean get-beget”
Sterie Ciumetti| Noi l-om crede când i-o crește bucățica ce-i lipsește...
Read More »Interviu EXPLOZIV cu doctorul TEODOR USCA
Sterie Ciumetti | Avertisment! Acest interviu vă poate afecta emoțional.
Read More »Am luat interviu unor elevi despre Holocaust
Sterie Ciumetti | Interviuri reale despre subiectul Holocaust, ce părere au elevii?
Read More »Interviu cu Mihai Șerban – Sânge, Lacrimi și Scântei!
Sterie Ciumetti | Interviu tăios despre problema militantismului vs. acțiune directă.
Read More »ÎN PLINĂ PANDEMIE Klaus Iohannis Majorează Salariul pentru Activiști Neomarxiști
Sterie Ciumetti | Citește și dă mai departe!
Read More »Episodul Ditrău- Lecțiile Rasiștilor
Sterie Ciumetti | Localnicii din Ditrău au făcut blitzkrieg.
Read More »Rabin Dizident Confirmă Adevărul Despre Talmud “ucide-l pe cel mai bun dintre ne-evrei!”
Incorect Politic | Porunca talmudică.
Read More »Adevărata Semnificație a Mioriței – Baciul eticii populare românești
Incorect Politic | Util deopotrivă pentru elevi și adulți.
Read More »Intelectualul Corect Politic Papahagi: “Naționalismul Are Ceva Profund Anticreștin”
Sterie Ciumetti | Șarpele din iarbă Papahagi împroașcă cu venin în Cluj-Napoca!
Read More »Fenomenul Piața Universității
Dan Cristian Ionescu | Am fost acolo, am trăit acele momente.
Read More »Planul Kalergi si Noua Ordine Mondială
MNR | Întreaga geopolitică din spatele planului Kalergi.
Read More »Fără Dezbinare – Mentalitatea Cooperării
Florin Bianu | Apel la consolidarea comunității!
Read More »România, azi
Costinel Petrache | îi este greu, triumfă-n jilțuri hoții...
Read More »Limba Maghiară Oficială?? Asociația Calea Neamului Solicită Abrogarea OUG-ului pe Codul Administrativ
Incorect Politic | O altă încălcare a Constituției și politicienii nu reacționează.
Read More »PATRIOȚI EXECUTAȚI, UCIȘI IN BĂTAIE SAU LĂSAȚI SĂ CRAPE DE FOAME ORI BOALĂ ÎN TEMNIȚELE BOLȘEVICE
Dan Cristian Ionescu | O listă întocmită în 24 de ore.
Read More »Angajat Concediat în România Pentru o Opinie
Sterie Ciumetti | Un precedent periculos. Alea iacta est
Read More »Vizita Papei – Autonomie Alternativă
Alexandru Inspirație | Vizita Papei și autonomia maghiarilor, istorie alternativă
Read More »Împotriva Fatalismului
Sterie Ciumetti | Un erou își făurește soarta.
Read More »Cum îți Programează (((Hollywood))) Mintea – Partea a II-a
Marea Trezire | Studiu de caz.
Read More »INTERVIU INCENDIAR cu Doamna Profesoară Iulia Radulescu
Sterie Ciumetti | Profesoara rupe tăcerea.
Read More »Ce Poate Învăța Europa de la Moriori
Sterie Ciumetti | Toleranța este lașitate.
Read More »Despre Adevăr
Sterie Ciumetti | Adevărul se merită.
Read More »Cum s-a Bucurat Suedia de Progresism și Multiculturalism în 2018
MNR | Suedia anului 2018.
Read More »Știrile PROTV- Jurnalism la Nivel Înalt INFORMAȚII DE INTERES PUBLIC!
Sterie Ciumetti | ATENȚIE! INTERES PUBLIC!!!
Read More »Evreii din Presa Mondială
Dan Cristian Ionescu | Fragment din cartea mea, Codul lui Lucifer.
Read More »Adevărul Despre Revoluție
Mihail | Incomod și dureros, acesta este adevărul.
Read More »Puneți-vă Tot Mai Multe Întrebări
Marea Trezire | Pui întrebări, nu dai cu paru'...
Read More »Ce Este Agenda Homosexuală si Mișcarea LGBTQpedo
MNR | Investigație ce ridică tensiunea.
Read More »“Vrem Să Reinventăm Rap-ul Românesc” – Interviu FORMIDABIL cu Calu’ Troian
Sterie Ciumetti | Interviu Calu' Troian.
Read More »Ce Este Planul Kalergi și De Ce Este Relevant
Sterie Ciumetti | Teorie a conspirației sau agendă planificată?
Read More »Albii vs. Industria de Divertisment
MNR | Asistăm la construcția glorioasă a socialismului multiculturalismului!
DREPTUL LA INSURECȚIE
Majadahonda | Sic semper tyrannis.
Read More »Cine e în Spatele Proiectului Roșia Montană
Mihail Incorect Politic Noiembrie 16, 2018 Cine se află de …
Read More »Multiculturalism în România – Viol, Crimă și Incendiu în Capitală
Multiculturalism în România.
Read More »Activismul din România, #rezist, Portrete de „Tefeliști” (Tineretul Frumos și Liber) de Profesie „Mitingiști” (II)
Incorect Politic | Despre activismul de la noi (care nu e defapt de la noi).
Read More »Cum funcționează Activismul (I)
MNR | Vrem spitale, nu catedrale?!
Read More »Cum Îți Programează (((Hollywood))) Mintea
Marea Trezire | Pilula roșie e amară, dar necesară.
Read More »“Oracolul de la Dămăroaia” și (((Democrația))) Românească
Mihail | Niște coincidențe...
Read More »Cine a Tras (De Fapt) În Noi?
Mihail | Magicienii dintre noi.
Read More »Organizația ANTIFA, de la Origini Până la Soroș
MNR | Dă-l mai departe.
Read More »EXPLOZIV ȘI EXCLUSIV: Interviul INTERZIS în Presa Românească
Un interviu incorect politic.
Read More »Suedia: Feminism, Corectitudine Politică, Multiculturalism și Socialism, Rețetă Sigură Pentru Dezastru
MNR Incorect Politic Ianuarie 11, 2018 Cine încearcă să înțeleagă …
Read More » Incorect Politic O Publicație Dizidentă
Incorect Politic O Publicație Dizidentă